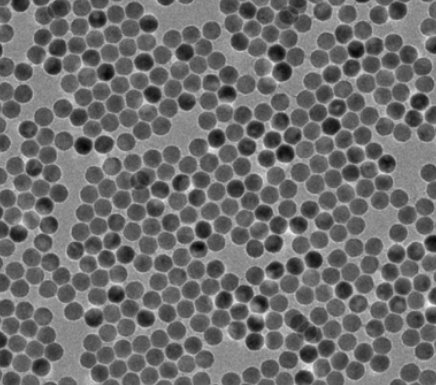
水溶性/油溶性上转换纳米颗粒 水溶性/油溶性上转换纳米颗粒

水溶性/油溶性上转换纳米颗粒
稀土纳米颗粒的发光不具有量子尺寸效应,相对于尺寸较大的化合物,纳米微粒具有更大的比表面积,因此处于表面的激活离子比例也高于相应的体相材料。由于纳米颗粒的边界阻断作用,能量的共振传递也只发生在单个微粒内部,所以高的猝灭浓度使其性能降低。在稀土纳米颗粒外部包覆同质稀土层、二氧化硅以及聚合物是**提高上转换发光效率以及量子产率的方法,同时多层结构还可以丰富发光色彩。
1: 同质壳 由于低声子能稀土壳的存在可以减少能量转移,降低稀土离子的自猝灭,因此在稀土纳米颗粒外部包覆同质的材料可以在很大程度上提高发光效率。Yi等人在掺杂Yb3+、Er3+
的NaYF4纳米颗粒外包覆了未掺杂的NaYF4和聚丙烯酸(PAA)后,荧光效率提高7.4倍;NaYF4BYb,Tm@NaYF4@PAA比单纯的NaYF4BYb,Tm纳米颗粒的荧光增强29.6倍。包覆KYF4的KYF4BYb,Er纳米颗粒的发光效率可以提高25倍。不同合成方法制备的核壳纳米颗粒的荧光增强程度是不一样的,Mai制备的A2NaYF4BYb,Er@A2NaYF4的上转换荧光效率增强一倍,而B2NaYF4BYb,Er@A2NaYF4的荧光只增加1/2
2 :异质壳 稀土上转换纳米颗粒包覆异质壳主要是为了获取水溶性、稳定性和分散性更好的材料,同时还可以使其表面富有功能基团。当有机配体是高能的C)H或者C)C,振动就会对镧系离子的发光造成严重猝灭。不同有机配体对稀土纳米颗粒的下转换发光略有影响,但对上转换发光的影响尚未有报道。异质材料对上转换氟化物纳米颗粒的包覆主要是二氧化硅、聚乙烯吡咯烷酮、聚丙烯酸、聚乙烯亚胺、聚丙烯胺、聚赖氨酸、聚乙二醇衍生物等等,包覆后上转换荧光有小幅度增强或者没有明显变化。
厂家:西安齐岳生物科技有限公司
用途:科研
状态:固体/粉末/溶液
产地:西安
温馨提醒:仅供科研,不能用于人体实验
相关产品:
SPPC沉积稀土上转换纳米发光颗粒
离子体光子晶体沉积稀土上转换颗粒
NaYF4:Yb,Er稀土掺杂上转换纳米颗粒
发射波长365nm上转换纳米颗粒
发射波长475nm上转换纳米发光颗粒
发射峰550nm稀土上转换纳米材料
发射波长660nm稀土上转换发光粒子
发射波长804nm稀土上转换UCNPS




 齐岳微信公众号
齐岳微信公众号
 官方微信
官方微信
 库存查询
库存查询